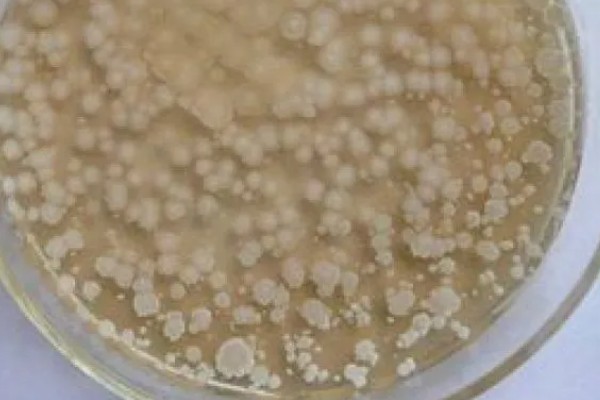
高粱黑葱花霉根腐病怎么防治，采取高垄或高畦栽培可减轻发病

防治方法:实行三年以上轮作,合理控制种植密度,采取高垄或高畦栽培。有机肥施加前需进行充分腐熟发酵处理,雨后需及时排水,切忌大水漫灌。
症状表现:主要危害高粱根部,苗期及成株期均可能发病。苗期发病时,主要表现为缺水、病苗皮层、维管束呈褐色水渍状,细根软化并腐烂。

一、高粱黑葱花霉根腐病怎么防治
1、危害高粱根部,苗期和成株期都有可能发病,苗期会出现缺水的现象,病苗皮层、维管束都会呈现出褐色水渍状,细根软化并腐烂。

2、防治方式是要实行三年以上的轮作,加强田间管理,栽种密度适宜,可用高垄或高畦栽培,尽可能不要在低洼地种植高粱,要施用充分腐熟的有机肥或者酵素菌沤制的堆肥,雨后田地里要注意排水,尽量不要大水漫灌。

二、高粱炭腐病的防治方法
1、收获后及时病残体 , 集中深埋或烧毁以减少菌源。
2、有条件的可与稻、麦轮作。

3、施用酵素菌沤制的堆肥 , 注意增施钾肥 , 以增强寄主抗病力。
4、 木素木霉对此菌抑制作用强 , 可将其与钾肥混合制成抗生菌肥料施用。
5、必要时喷洒30%琥胶肥酸铜 ( 扫细 ) 悬浮剂500倍液或80%代森锰锌( 新万生 ) 可湿性粉剂600倍液 , 隔10天1次 , 连续防治2-3次。